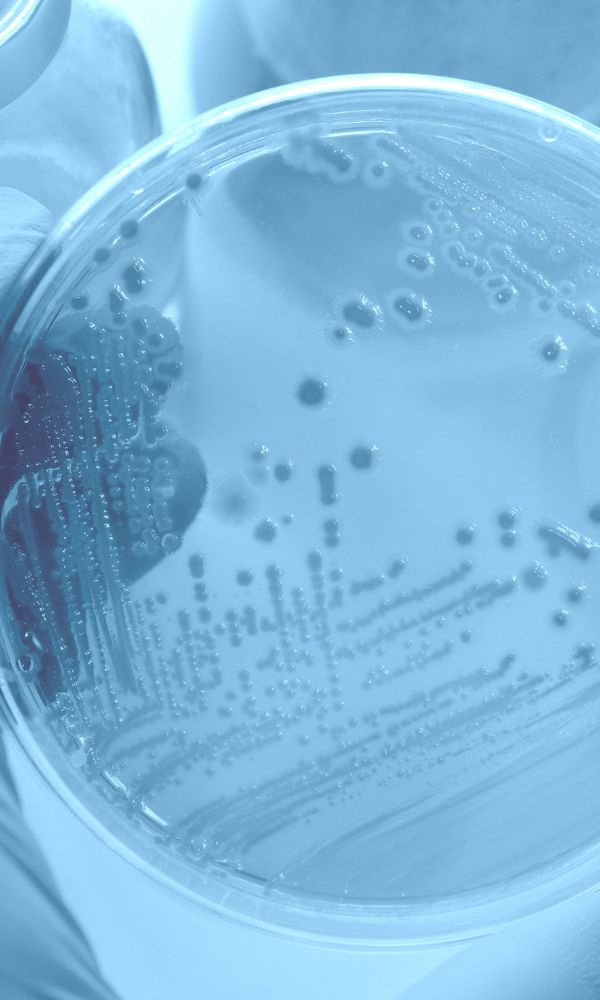

Explore our full range of gut health supplements—formulated to restore balance, resilience, and vitality from within. Every product is made with care, guided by science, and designed to support you from within.
Supports gut health with targeted solutions for all ages, promoting balance and resilience for a healthier you.
€ 119,95 incl. VAT
A next‐generation healthy aging gut support, formulated with 2’-FL, Triple Bifidus, and MGCPQQ®.
€ 24,95 incl. VAT
A high-purity L-glutamine supplement, supporting gut barrier integrity, immune health, and personalized dosing for tailored gut support.
€ 59,95 incl. VAT
Advanced daily gut health supplement combining prebiotics galacto-oligosaccharides and 2′-fucosyllactose, probiotics Bifidobacterium longum BB536, and L-Glutamine for microbiome balance and gut integrity.
Nourishes skin from within, layer by layer, through advanced formulations that support radiance, elasticity, and the gut–skin axis.
€ 269,85 Original price was: € 269,85.€ 214,95Current price is: € 214,95. incl. VAT
Consistency meets radiance. A 3-month supply of Skinbiotica COLLAGEN+—science-backed skin nutrition to support skin collagen, elasticity, and glow from within.
€ 209,90 Original price was: € 209,90.€ 179,95Current price is: € 179,95. incl. VAT
Complete beauty from within—Gutbiotica PRIME provides comprehensive microbiome support while Skinbiotica COLLAGEN+ promotes radiant and elastic skin.
€ 89,95 incl. VAT
Science-backed beauty from within: collagen tripeptides for the dermis, Ceramosides™ for the barrier, and probiotics + prebiotics for the gut-skin axis. All in one daily serving.
Formulated to gently fuel your microbiome, support digestion, and promote metabolic balance. Powered by the essential, often-missing fiber.
€ 44,95 incl. VAT
An advanced fiber supplement combining glucomannan, Fibersol®, and GOS to support weight loss, promote satiety, and nourish your gut microbiota.
€ 34,95 incl. VAT
A smart blend of psyllium husk, Fibersol®, and FOS designed to promote regularity, digestion, and microbiome balance—gently and effectively.
Curated combinations for deeper results. Targeted support for gut, skin, shape, and beyond. At better value, with simplicity built in.
€ 269,85 Original price was: € 269,85.€ 214,95Current price is: € 214,95. incl. VAT
Consistency meets radiance. A 3-month supply of Skinbiotica COLLAGEN+—science-backed skin nutrition to support skin collagen, elasticity, and glow from within.
€ 209,90 Original price was: € 209,90.€ 179,95Current price is: € 179,95. incl. VAT
Complete beauty from within—Gutbiotica PRIME provides comprehensive microbiome support while Skinbiotica COLLAGEN+ promotes radiant and elastic skin.
€ 164,90 Original price was: € 164,90.€ 139,95Current price is: € 139,95. incl. VAT
A smart pairing for gut microbiome and weight support with Gutbiotica CORE and Fibersentials SHAPE to maintain a happy gut and support satiety naturally.
€ 104,90 Original price was: € 104,90.€ 94,95Current price is: € 94,95. incl. VAT
Gut health and weight loss bundle with Gutbiotica CORE and Fibersentials SHAPE to maintain a happy gut while supporting your shape—one smart duo for everyday use.
€ 94,90 Original price was: € 94,90.€ 84,95Current price is: € 84,95. incl. VAT
Daily gut balance and fiber support with Gutbiotica CORE and Fibersentials FLOW. Probiotic, prebiotic, and fiber synergy for complete gut balance.
Because it supports you: your digestion, immunity, mood, skin, and more. A well-balanced gut microbiome influences nearly every aspect of your health. When your gut is in balance, everything else runs smoother.
You can dive deeper into the science and see why your gut truly matters here.
We combine science-backed ingredients in effective doses. No fillers, no fluff. Each formula is thoughtfully crafted to work in synergy, inspired by evolutionary biology and the needs of modern life. We also keep things simple: no unnecessary complexity, just results that matter.
Yes, our gut health supplements are made to complement one another and are even more effective when taken together. Each formula is a building block in your routine, designed to work synergistically for optimal results.
Explore our Bundle & Save options to see curated pairings and save while you’re at it.
Everyone’s different, and so are our products. While some may feel benefits sooner, many notice improvements within 30–60 days. We use ingredients that are clinically studied and dosed for real impact, so your results are built to last.
Our gut health supplements are made for everyone who wants to support their gut health, regardless of gender. Most formulas are designed for adults (18+), but some, like Fibersentials FLOW, may benefit younger users too. For children or if you’re pregnant, nursing, or managing a condition, we always recommend consulting to a healthcare professional first.
We want you to enjoy your AB INTRA experience. If you’re not satisfied, you can return unopened, unused items within 30 days of receipt. As our products are ingestible, we can only offer a full refund if all seals are intact. Please note: original shipping costs are non-refundable, and return shipping is at the customer’s expense. For full details, please see our Return Policy.
Our approach is rooted in authenticity, independence and purposeful science.

Phylogenetic tree illustrating the genomic diversity of the human gut microbiota, adapted from Almeida, A., Mitchell, A.L., Boland, M. et al. A new genomic blueprint of the human gut microbiota. Nature 568, 499–504 (2019). Licensed under CC BY 4.0. View original article.
Committing to three months was worth it. My skin feels more hydrated and smooth, and I actually look forward to taking it every day.
This is my favorite. I take it daily and my skin looks fresher while my digestion feels calmer. It’s nice to see results inside and out.*
I was looking for something to support both metabolism and gut health. This duo works! I feel satisfied for longer and my digestion has improved too.*
This combo really clicked for me. My stomach feels more settled and I don’t get the same sugar cravings in the afternoon. It fits my weight goals without being complicated.*
I wanted something simple to keep my gut in balance. Taking CORE and FLOW together feels complete, my digestion has been smoother and I feel lighter overall.
Glucomannan is one of the few EFSA-approved ingredients for weight loss, I love that this blend is science-backed and clean.*
Cookies help us keep things running smoothly — and sometimes sweetly. We use them to improve your experience. You choose what to keep.
Here you decide how much you’d like to share. Some cookies are essential — they keep the site functional. Others help us learn and improve. The choice is yours.
These cookies make the site work. Without them, basic functions would fail.
Google Tag Manager simplifies the management of marketing tags on your website without code changes.
These cookies help us understand how people use the site — collected anonymously.
Google Analytics is a powerful tool that tracks and analyzes website traffic for informed marketing decisions.
Service URL: policies.google.com
SourceBuster is used by WooCommerce for order attribution based on user source.
You can find more information in our Cookie Policy and Privacy Policy.